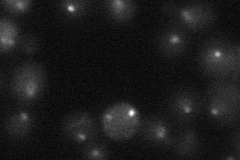
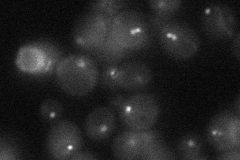

View description
Subunit of a kinetochore-microtubule binding complex with Kre28p that bridges centromeric heterochromatin and kinetochore MAPs and motors; required for sister chromatid bi-orientation and kinetochore binding of SAC components
Localization:
Intensity:
Fold change:
Significance:
-
C’ GFP library in SD

punctate23.12 -
N' NOP1pr-GFP in SD

punctate,nucleus38.6485 -
N' TEF2pr-mCherry in SD
punctate,nucleusN/A -
N' NATIVEpr-GFP in SD
punctate20.4923 -
N' TEF2pr-VC and Cyto-VN in SD

punctate25.4141 -
C’ GFP library in SD+DTT

punctate23.070.99No -
C’ GFP library in SD+H2O2

punctate21.810.94No -
C’ GFP library in Starvation Media

punctate20.260.87No -
C’ GFP library on the background of Pup2-DaMP

punctate -
C’ GFP library on the background of CCT mutant

punctate25.01551.08154No
